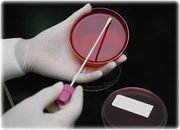

Uploads by Cporteous
This special page shows all uploaded files.
| Date | Name | Thumbnail | Size | Description | Versions |
|---|---|---|---|---|---|
| 17:46, 12 March 2010 | Glottis.jpg (file) |  |
30 KB | transtracheal wash | 1 |
| 17:36, 12 March 2010 | Culture copy.jpg (file) | |
20 KB | swab for lizard and snake diagnostics | 1 |
| 14:32, 9 March 2010 | Boa stomatitis ed.jpg (file) |  |
26 KB | ulcerative stomatitis in boa | 1 |
| 14:04, 9 March 2010 | 0051 BLISTER DISEASE PYTHON ed.jpg (file) |  |
19 KB | blisters on snake skin | 1 |
| 13:58, 9 March 2010 | Boa with dys ed.jpg (file) |  |
30 KB | dysecdysis in boa | 1 |
| 12:55, 9 March 2010 | Steth crop.jpg (file) |  |
28 KB | Snake Physical Examination | 1 |
| 11:09, 4 March 2010 | Glove and hook.jpg (file) |  |
105 KB | Snake safety equip. | 1 |
| 11:06, 4 March 2010 | Snake hook 1.jpg (file) |  |
6 KB | Safely restraining venemous snakes | 1 |
| 11:02, 4 March 2010 | Snakeheadhold.jpg (file) |  |
175 KB | Royal python restraint | 1 |
| 14:54, 2 March 2010 | Snake eating mouse ed.jpg (file) |  |
16 KB | Adult snake eating adult mouse | 1 |
| 14:50, 2 March 2010 | Snake eating baby mouse.jpg (file) |  |
11 KB | Snake Feeding - what size | 1 |
| 14:28, 2 March 2010 | Snakevisualsecurity.jpg (file) |  |
184 KB | Green snake on branch in vivarium | 1 |
| 14:12, 2 March 2010 | Light4.JPG (file) |  |
262 KB | Light bulb for Snake Housing | 1 |
| 16:45, 25 February 2010 | Burmese python heart in situ.jpg (file) |  |
70 KB | Snake heart - cardiovascular system | 1 |
| 16:14, 25 February 2010 | No external ear - 718008 copy.jpg (file) |  |
12 KB | Photo of snake head showing no external ear | 1 |
| 16:07, 25 February 2010 | Pit viper pits - 718041.jpg (file) |  |
6 KB | Pit viper heat pits - special senses | 1 |
| 15:56, 25 February 2010 | Boid pits - 789012.jpg (file) |  |
5 KB | Boid heat pits | 1 |
| 15:25, 25 February 2010 | SpecSense 330.bmp (file) |  |
49 KB | Snake head diagram for chemoreception | 1 |
| 15:38, 16 February 2010 | Round yellow rat snake pupil.jpg (file) |  |
5 KB | The Eye - round pupil | 1 |
| 15:38, 16 February 2010 | Slit palm pit viper pupil.jpg (file) |  |
4 KB | The Eye - slit pupil | 1 |
| 15:31, 16 February 2010 | Long-nosed snake ed.jpg (file) |  |
16 KB | which of theses snakes are poisonous? | 1 |
| 15:30, 16 February 2010 | Corn snake ed.jpg (file) |  |
18 KB | which of these snakes are poisonous? | 1 |
| 15:30, 16 February 2010 | Coral snake ed.jpg (file) |  |
25 KB | which of these snakes are poisonous? | 1 |
| 15:29, 16 February 2010 | Rattle2.jpg (file) |  |
13 KB | which of these snakes is poisonous? | 1 |
| 15:28, 16 February 2010 | Viper teeth ed.jpg (file) |  |
13 KB | which of these snakes are poisonous? | 1 |
| 15:24, 16 February 2010 | Milk snake colour.bmp (file) | 11 KB | identifying non-venomous snake by colour | 1 | |
| 15:23, 16 February 2010 | Coral snake colour.bmp (file) | 11 KB | identifying venemous snake | 1 | |
| 15:21, 16 February 2010 | Gaboonviperhead.jpg (file) |  |
6 KB | 1 | |
| 15:20, 16 February 2010 | Gaboon viper fangs.jpg (file) |  |
233 KB | Fangs for snake anatomy | 1 |
| 15:18, 16 February 2010 | Snake Anatomy.bmp (file) |  |
126 KB | Snake anatomy diagram for pop ups | 1 |
| 15:15, 16 February 2010 | Trans-pecos rat snake 240x180.jpg (file) |  |
25 KB | Rat snake | 1 |
| 13:34, 16 February 2010 | ROYAL PYTHON 240x180.jpg (file) |  |
14 KB | Royal python | 1 |
| 13:32, 16 February 2010 | Milk snake.jpg (file) |  |
12 KB | Milk snake | 1 |
| 13:31, 16 February 2010 | Kingsnake - 87012 240x180 border.jpg (file) |  |
22 KB | King snake | 1 |
| 13:30, 16 February 2010 | Garter snake240x180.jpg (file) |  |
14 KB | Garter snake | 1 |
| 13:30, 16 February 2010 | Cornsnake - 718047 240x180.jpg (file) |  |
22 KB | Corn snake | 1 |
| 13:29, 16 February 2010 | Burmese python 240x180 border.jpg (file) |  |
35 KB | Burmese python | 1 |
| 13:28, 16 February 2010 | Boa constrictor.BMP (file) |  |
444 KB | Boa constrictor | 1 |
| 13:26, 16 February 2010 | Snaketaxonomy.bmp (file) |  |
90 KB | Snake taxonomy map | 1 |
| 14:50, 9 February 2010 | Snakebite kit.jpg (file) |  |
43 KB | 1 | |
| 16:04, 5 January 2010 | Restraint.pdf (file) | 36 KB | 1 | ||
| 15:52, 5 January 2010 | Snake Diets.pdf (file) | 44 KB | 1 | ||
| 14:53, 5 January 2010 | AfricanHouseSnake.jpg (file) |  |
120 KB | 1 | |
| 19:37, 28 December 2009 | Commonboa.jpg (file) |  |
147 KB | 1 | |
| 19:32, 28 December 2009 | Boaconstrictor.jpg (file) |  |
117 KB | 1 | |
| 17:35, 28 December 2009 | Greetreepython.jpg (file) |  |
978 KB | 1 | |
| 15:30, 21 December 2009 | Snake Page.jpg (file) |  |
423 KB | 1 | |
| 19:09, 14 December 2009 | Pythonregius.jpg (file) |  |
828 KB | 1 | |
| 16:16, 28 September 2009 | Frog logo.jpg (file) |  |
14 KB | 1 | |
| 10:08, 11 September 2009 | Africanlionessbigstare.jpg (file) |  |
98 KB | 1 |